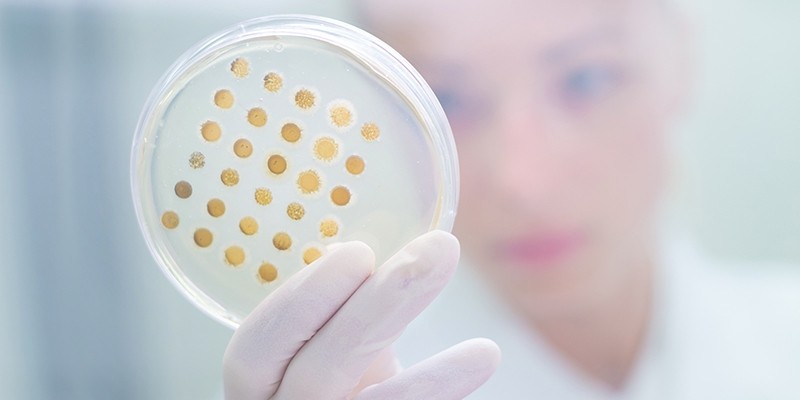
Can it be determined on the basis of laboratory analysis if something is a viral or bacterial infection?

Sponsored Content
Can it be determined on the basis of laboratory analysis if something is a viral or bacterial infection?
28 Feb 2023In order to distinguish between bacterial and viral infections and set the correct diagnosis, blood and urine analyses are done.
The main indicators of infection in blood analysis are: number of leukocytes and CRP.
If your child has an infection, you should contact your pediatrician. Doctors are the only ones qualified to interpret the results of the analysis.
The indicators interpreted by pediatricians as part of the child’s examination and diagnosis are the following:
For children up to the age of 3, if leukocytes are below ≤ 15,000 and CRP below ≤ 40, it is a viral infection. For children over the age of 3, if leukocytes are below ≤ 13,000 and CRP below ≤ 40, it is a viral infection. The pediatrician never forgets to monitor the physical state of a child! Do not try to interpret the results by yourself!
Nose swab
Very often during the examination, a nose swab is taken. A large number of bacteria lives in the nose, so nose swap should not be given because it has no practical value!
Related news

Benefits of using natural antioxidants in food
20 Nov 2025
The dietary habits of individuals are undergoing a transformation, with consumers increasingly seeking new, healthier, and higher-quality formulas. This shift signifies a growing awareness of food ingredients, including preservatives, additives, a...
Read more
Oat Barista: Innovation for game-changing beverages
20 Nov 2025
Oat Barista is a clean label, sustainable, and innovative drink base specifically designed to create the perfect foam in one single ingredient.
Read more
The Umami Renaissance: Clean Label & Cost Control with Ready-to-Use Fungal Bases
19 Nov 2025
Consumers demand authentic, rich flavor (Umami) and simple labels. The fungal protein market is growing at a 5.6% CAGR, offering manufacturers the solution: heat-stable, natural bases that eliminate prep costs and supply risks associated with raw wild ...
Read more
Azelis brings a taste of global street food innovation to Food Ingredients Europe 2025
18 Nov 2025
Azelis, the reference innovation service provider in the speciality chemicals and food ingredients industry, will showcase its latest Food & Nutrition innovations at Food Ingredients Europe (FiE) 2025, taking place from 2 to 4 December at Paris Expo Po...
Read more
PharmaLinea acquired by ANJAC Health & Beauty Group
18 Nov 2025
Ljubljana, 12.11. 2025 PharmaLinea, a leading provider of clinically supported private label food supplements has announced its acquisition by ANJAC Health & Beauty, a French industrial group that now comprises 17 complementary companies with R&D an...
Read more
The Heat Test: How Encapsulation and Bases are Ending the Multi-Billion Dollar Flavor Fade
18 Nov 2025
Flavor degradation during heat processing is a major financial risk in food manufacturing. In 2025, R&D is shifting to advanced encapsulation and heat-stable bases to protect volatile flavor compounds and ensure final product consistency.
Read more
Use Case Spotlight: Versatile Bases Solve Key Challenges in Ready Meals, Sauces, and Cheese
17 Nov 2025
Ready-to-use bases are the manufacturing solution for the $425 Billion RTE market. Our versatile ingredients solve core issues in three top categories: taste, clean-label compliance, and complex texture stability.
Read more
Hilmar Cheese & Whey Protein Awarded Medals
17 Nov 2025
Hilmar Cheese Company, Inc. was awarded top honors at the CheeseCon banquet celebrating the United States Championship Cheese Contest® on April 17, 2025.
Read more
Hilmar Cuts the Ribbon at New Dodge City Facility
17 Nov 2025
Hilmar Cheese Company, Inc., one of the world’s largest cheese manufacturers and a global supplier of high-quality whey ingredients was joined by Kansas Governor Kelly, U.S. Senator Moran and other federal, state and local officials to officially mark ...
Read more
Data Insight: Clean-Label Adoption Drives US$425 Billion Market, Prioritizing Simplicity and Natural Flavors
14 Nov 2025
The Clean Label Products market is projected to grow from US$425.32 billion in 2025 to over US$712 billion by 2034, driven by consumers prioritizing recognizability, minimal processing, and natural ingredient replacement.
Read more
